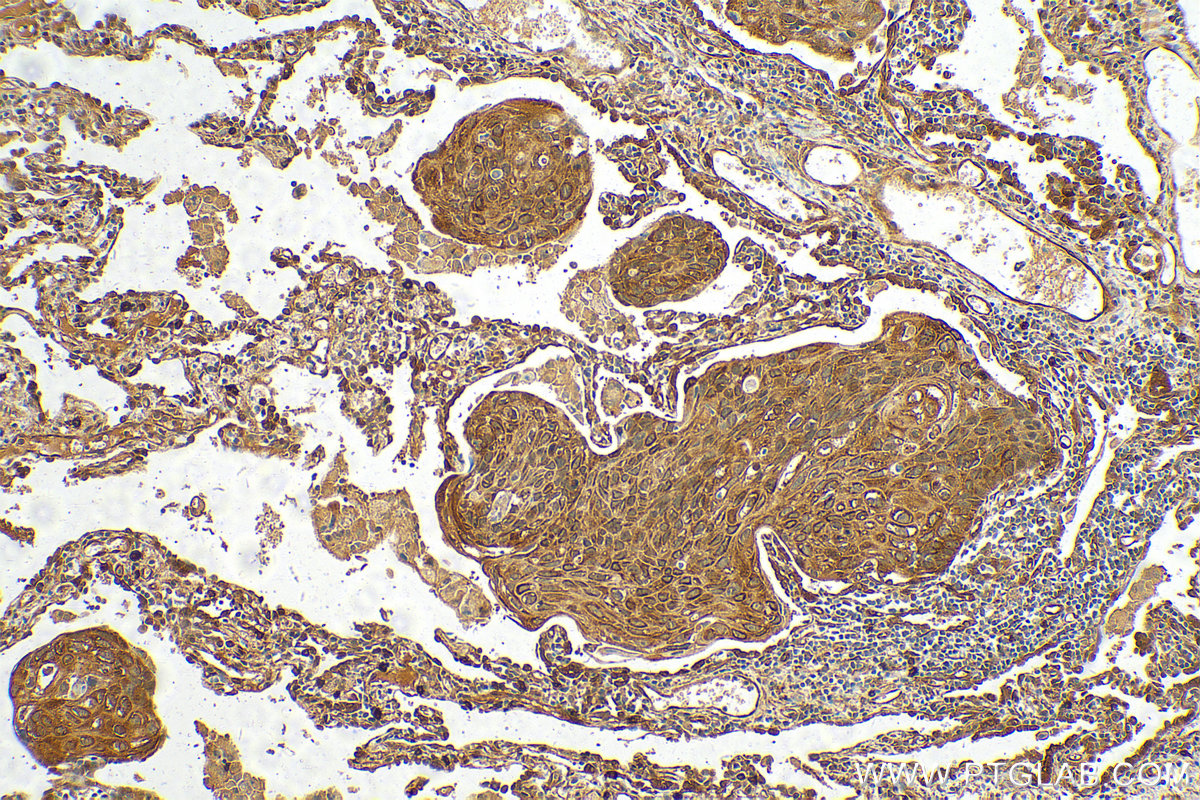

验证数据展示
经过测试的应用
| Positive WB detected in | HEK-293 cells, HeLa cells, K-562 cells, mouse heart, rat heart |
| Positive IP detected in | K-562 cells |
| Positive IHC detected in | human lung cancer tissue, human gliomas tissue Note: suggested antigen retrieval with TE buffer pH 9.0; (*) Alternatively, antigen retrieval may be performed with citrate buffer pH 6.0 |
| Positive IF/ICC detected in | A549 cells, HeLa cells, HepG2 cells |
推荐稀释比
| 应用 | 推荐稀释比 |
|---|---|
| Western Blot (WB) | WB : 1:30000-1:60000 |
| Immunoprecipitation (IP) | IP : 0.5-4.0 ug for 1.0-3.0 mg of total protein lysate |
| Immunohistochemistry (IHC) | IHC : 1:500-1:2000 |
| Immunofluorescence (IF)/ICC | IF/ICC : 1:50-1:500 |
| It is recommended that this reagent should be titrated in each testing system to obtain optimal results. | |
| Sample-dependent, Check data in validation data gallery. | |
产品信息
10599-1-AP targets BAG3 in WB, IHC, IF/ICC, IP, CoIP, ELISA applications and shows reactivity with human, mouse, rat samples.
| 经测试应用 | WB, IHC, IF/ICC, IP, ELISA Application Description |
| 文献引用应用 | WB, IHC, IF, IP, CoIP |
| 经测试反应性 | human, mouse, rat |
| 文献引用反应性 | human, mouse, rat, monkey, hamster |
| 免疫原 |
CatNo: Ag0956 Product name: Recombinant human BAG3 protein Source: e coli.-derived, PGEX-4T Tag: GST Domain: 275-575 aa of BC006418 Sequence: SREGSPARSSTPLHSPSPIRVHTVVDRPQQPMTHRETAPVSQPENKPESKPGPVGPELPPGHIPIQVIRKEVDSKPVSQKPPPPSEKVEVKVPPAPVPCPPPSPGPSAVPSSPKSVATEERAAPSTAPAEATPPKPGEAEAPPKHPGVLKVEAILEKVQGLEQAVDNFEGKKTDKKYLMIEEYLTKELLALDSVDPEGRADVRQARRDGVRKVQTILEKLEQKAIDVPGQVQVYELQPSNLEADQPLQAIMEMGAVAADKGKKNAGNAEDPHTETQQPEATAAATSNPSSMTDTPGNPAAP 种属同源性预测 |
| 宿主/亚型 | Rabbit / IgG |
| 抗体类别 | Polyclonal |
| 产品类型 | Antibody |
| 全称 | BCL2-associated athanogene 3 |
| 别名 | BAG-3, Bcl-2-associated athanogene 3, Bcl-2-binding protein Bis, BIS, Docking protein CAIR-1 |
| 计算分子量 | 61 kDa |
| 观测分子量 | 74-80 kDa |
| GenBank蛋白编号 | BC006418 |
| 基因名称 | BAG3 |
| Gene ID (NCBI) | 9531 |
| RRID | AB_2062602 |
| 偶联类型 | Unconjugated |
| 形式 | Liquid |
| 纯化方式 | Antigen affinity purification |
| UNIPROT ID | O95817 |
| 储存缓冲液 | PBS with 0.02% sodium azide and 50% glycerol, pH 7.3. |
| 储存条件 | Store at -20°C. Stable for one year after shipment. Aliquoting is unnecessary for -20oC storage. |
背景介绍
BAG3 (Bcl2-associated athanogene 3) belongs to the BAG protein family, the co-chaperone that binds to Hsc70/Hsp70 through the BAG domain and modulates their activity in polypeptide folding. BAG3 contains also a WW domain and a proline-rich (PXXP) repeat, that mediate binding to partners different from Hsp70. Through interacting with different molecular partner, BAG3 influences several cell processes, such as apoptosis, autophagy and cell motility. BAG3 protein has been reported to sustain cell survival, resistance to therapy, and/or motility and metastatization in several tumor types, thus being identified as a potential target for anticancer therapies. In addition, defects in BAG3 are the cause of some myopathy. BAG3 normally migrates around 74-80 kDa; a slightly different molecular weight or a doublet form can be observed in some cell types and/or following cell exposure to stressors. A synaptosome associated form of 40 kDa has recently been described.
实验方案
| Product Specific Protocols | |
|---|---|
| IF protocol for BAG3 antibody 10599-1-AP | Download protocol |
| IHC protocol for BAG3 antibody 10599-1-AP | Download protocol |
| IP protocol for BAG3 antibody 10599-1-AP | Download protocol |
| WB protocol for BAG3 antibody 10599-1-AP | Download protocol |
| Standard Protocols | |
|---|---|
| Click here to view our Standard Protocols |
发表文章
| Species | Application | Title |
|---|---|---|
Nat Genet Mutations affecting the cytoplasmic functions of the co-chaperone DNAJB6 cause limb-girdle muscular dystrophy. | ||
Nat Neurosci A tau homeostasis signature is linked with the cellular and regional vulnerability of excitatory neurons to tau pathology.
| ||
Acta Neuropathol Missense mutations in small muscle protein X-linked (SMPX) cause distal myopathy with protein inclusions. | ||
J Intern Med Transglutaminase type 2 plays a key role in the pathogenesis of Mycobacterium tuberculosis infection. | ||
Nat Commun Misfolded polypeptides are selectively recognized and transported toward aggresomes by a CED complex. | ||
Nat Commun Cardiomyocyte contractile impairment in heart failure results from reduced BAG3-mediated sarcomeric protein turnover. |